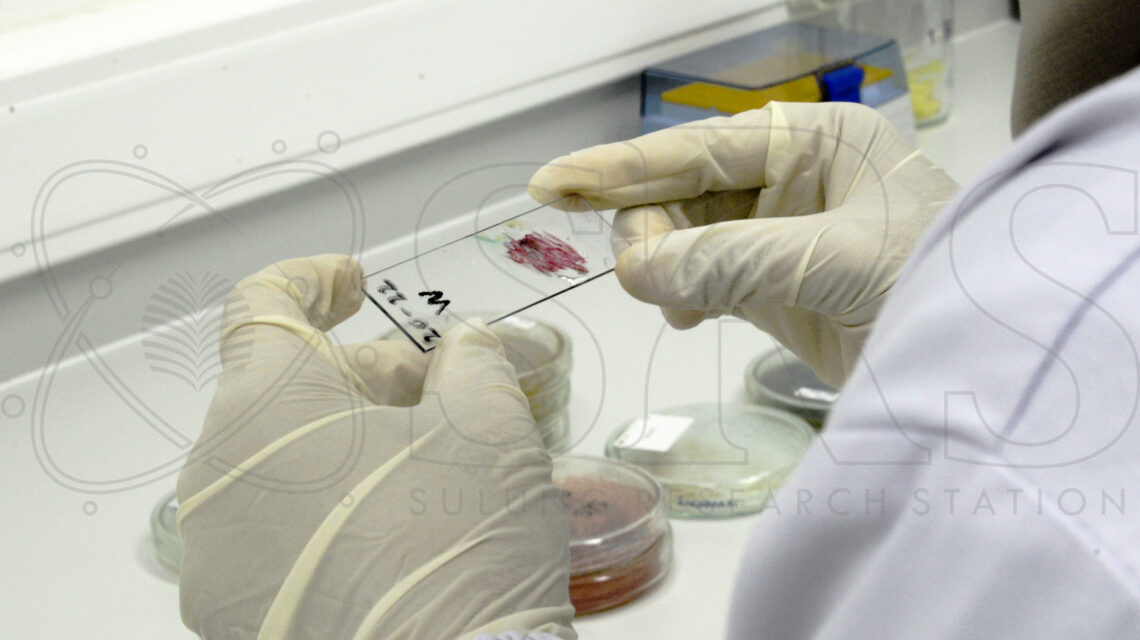
mikroorganisme kelapa sawit

Sulung Research Station (SRS) menggelar konsolidasi internal sebagai upaya memperkuat sinergi antar divisi serta mendorong pertukaran ide dan informasi terkini terkait berbagai…

Industri kelapa sawit menjadi sektor unggulan dengan kontribusi besar bagi perekonomian Indonesia, dimana Crude Palm Oil (CPO) menjadi komoditas ekspor utama setelah…

Salah satu tantangan utama dalam pengembangan perkebunan kelapa sawit diantaranya adalah lahan marjinal. Umumnya, lahan ini memiliki kualitas tanah yang rendah, seperti…

Dalam usaha budidaya kelapa sawit, lahan menjadi salah satu faktor utama yang menentukan tingkat produktivitas. Lahan tidak hanya dipahami sebagai tanah secara…
Tanah merupakan media tanam yang sangat penting bagi komoditas tanaman budidaya, bukan hanya karena jumlah ketersediaan tanah yang digunakan hampir pada sebagian…

Beneficial Plant Kelapa Sawit - Sebagai perusahaan perkebunan kelapa sawit berkelanjutan, PT SSMS Tbk. terus berinovasi dalam menjaga lingkungan dan meningkatkan produktivitas…

Biofertilzer Kelapa Sawit - Penggunaan pupuk kimia dalam industri perkebunan kelapa sawit secara terus menerus dapat merusak kesimbangan hara di dalam tanah.…

Asam Humat - Laboratarium Sulung Research Station (SRS), PT Sawit Sumbermas Sarana Tbk. (PT SSMS Tbk.) terus melakukan penelitan dan inovasi terhadap…

Penyerbukan Kelapa Sawit - Tanaman kelapa sawit sebagai tanaman berumah satu yang memiliki bunga jantan dan bunga betina berada pada tandan yang…

Janjang Kosong Kelapa Sawit - Peningkatan produktivitas industri kelapa sawit yang tinggi harus diimbangi dengan pengelolan limbah yang bertanggung jawab dan ramah…



